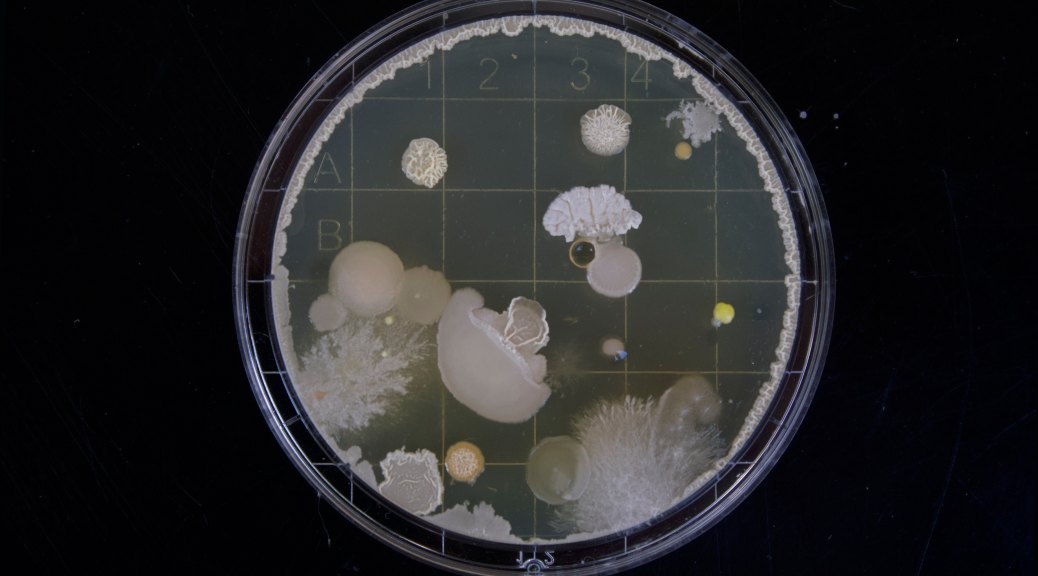

I gave one of the nurses at my office a about 40 lbs. of tomatoes this year, since she wanted to make salsa. We had an abundance and I was glad to get rid of them. She said she got other tomatoes, too, and canned 60 jars of salsa. She gave me a jar earlier this week, and it was all I could do to smile and thank her when she handed it to me. Once I got up to my floor, I flushed it down the toilet.
Perhaps I am overly cautious, but I would never can and process anything in a used Hormel ham hock jar using the original cap. She hadn’t even removed the ham hock label. I know that salsa has lots of acid in it from the vinegar, and that her salsa will probably be fine, but, still, this person is a nurse and there are some basic rules of hygienic food preservation that you just never violate. There was a story in the Fargo Forum a few years back about some well meaning woman in the eastern part of the state who invited people for Sunday dinner, fed them home canned peas, and killed half of the guests with botulism. Those stories stick with a person who does any home canning.
Tell about some gifts you would have rather not received. Got any canning or food preservation disasters or horror stories? Am I being alarmist?

My father in law does canning and is cautious about his hygiene and the rules of the road.
He has food that he goes to the trouble of canning and then he has some things like refrigerator pickles he puts in jars and says he will keep in the fridge for up to 6 months without being concerned
His salsa is good but a time line of 30 days is what he instructs as he hands it out.
Next year I will do tomatoes. I love home made salsa and sauces
Are you being alarmist?
Yes but I would guess that you are justified if she did it this way. She should have given it to you in Tupperware with a 30 day window.
I found a jar of mama chester’s Honduran Chile sauce canned properly and in my cupboard 2 years after she died. I enjoyd me eggs and her memory for a month or two after I found it. She made the best Chile sauce ever.
New I pad mini makes eliminating caps too much work. I will look into lower case default. I am not a fan of uppercase.
LikeLiked by 4 people
Doesn’t she read the directions?? Everything I’ve seen says you have to have a seal provided by those special lids and a hot (boiling)water bath… I’m with you, Renee.
That said, I cut corners where others are much more careful. And I read this week about some things that don’t need refrigeration, like ketchup and maple syrup – many foods have enough salt or sugar that act as a natural preservative.
Will answer the actual question later…
LikeLiked by 1 person
Never trust anyone who eats ham hocks out of a jar.
LikeLiked by 5 people
I guess I don’t blame you for not eating salsa out of a ham hock jar. I don’t do canning, but if I was making foodstuffs for other people, I would be extra careful. Personally, I’m not fussy and germs and bacteria don’t scare me. I live by the ten second rule and have no problems. 🙂
Actually, the latest health research on our microbiome shows that we are far more bacteria than we are human. We need a diverse microbiome inside and outside of us to be truly healthy and have a strong immune system. All these anti-bacterial soaps, hand sanitizers, etc., are taking it just a tad too far. Obviously, good hygiene is important and has eradicated many diseases. But all this fear-mongering and excessive antiseptic attitude is not helping us overall.
LikeLiked by 2 people
Yay! (“Like” was just so flimsy for this comment.)
LikeLike
I canned for many years but I have to admit the last 10 years I’ve gone more toward freezing instead. It’s just so much easier.
And I agree with JoAnne that you’re not being alarmist. I’m not sure I would eat it out of a ham hock jar without a good sealed lid either.
LikeLike
Yes – freezing stuff here too. “They” say to freeze certain things for only X number of months, but I’ve gone way over that limit a number of times, and never been harmed.
LikeLiked by 2 people
if she brought it in. bowl is pull out a bag of chips
LikeLike
I’m thinking may be is was meant to be I’d?
LikeLike
When I was teaching, parents of the kids often felt compelled to give me a little Christmas gift – even in 1971 there were mugs etc. that said “Greatest Teacher”, etc., on them And when I had a rabbit collection, I was given all kind of cutesy bunnies dressed like people, when what I liked were natural looking bunnies… Finally stopped doing both of those things, and rarely get something I don’t like.
I now get lots of books as gifts – if I get a book I’m not particularly interested in, there are lots of good places to relocate them…
LikeLiked by 1 person
My mom sometimes got home-canned meat from some of her students. She couldn’t bring herself to eat it.
LikeLiked by 1 person
Most of my friends know better than trying to surprise me with a book except one. She keeps trying but even the last cookbook she purchased for me was a duplicate! The library book sale is a good home for these!
LikeLiked by 1 person
I have a pretty relaxed attitude about food if I have confidence in the personal hygiene of the person who made it. As I read your account of this salsa, I’m not sure whether this jar of salsa was actually canned. If it was fresh salsa, and she had just used the Hormel jar to store it in for consumption within the next few days, I’d have tried it. Can you even get a used lid to seal properly? Have never tried to do that, I just know using a used lid as a definite no-no. On the other hand, if that’s how she has canned 60 jars of salsa, perhaps her canning skills are a little suspect. It pains me, though, to think that a good jar of salsa might have been flushed down the toilet. I love salsa, and I make a good one, if I may say so myself.
LikeLiked by 3 people
No, this was sealed. The button in tbe middle of the lid was down, and it made that noise when you open a sealed jar.
LikeLike
I enjoyed BBC mystery some years ago called “Of His Malice Aforethought” in which a physician cultivated Botulism spores and poisoned his wife, making it look like a food preservation accident. He was found out, of course.
LikeLiked by 2 people
OT… I brought all the vinyl down from the attic for Sunday… I don’t know if any baboons besides our tim still have turntables, but everything is for the taking!
LikeLike
LOL – there is a Death by Salsa out there!!! I’ll try to get it through MNLink!
LikeLiked by 2 people
If I was suspicious about the salsa, I might have used it in a batch of black bean soup. Boiling kills most pathogens, except the toxins that are produced by botulism. But botulism takes a long time to produce toxins, so if it was a recent vintage, I wouldn’t worry about that too much. Like PJ, I’d hate to waste it.
LikeLiked by 1 person